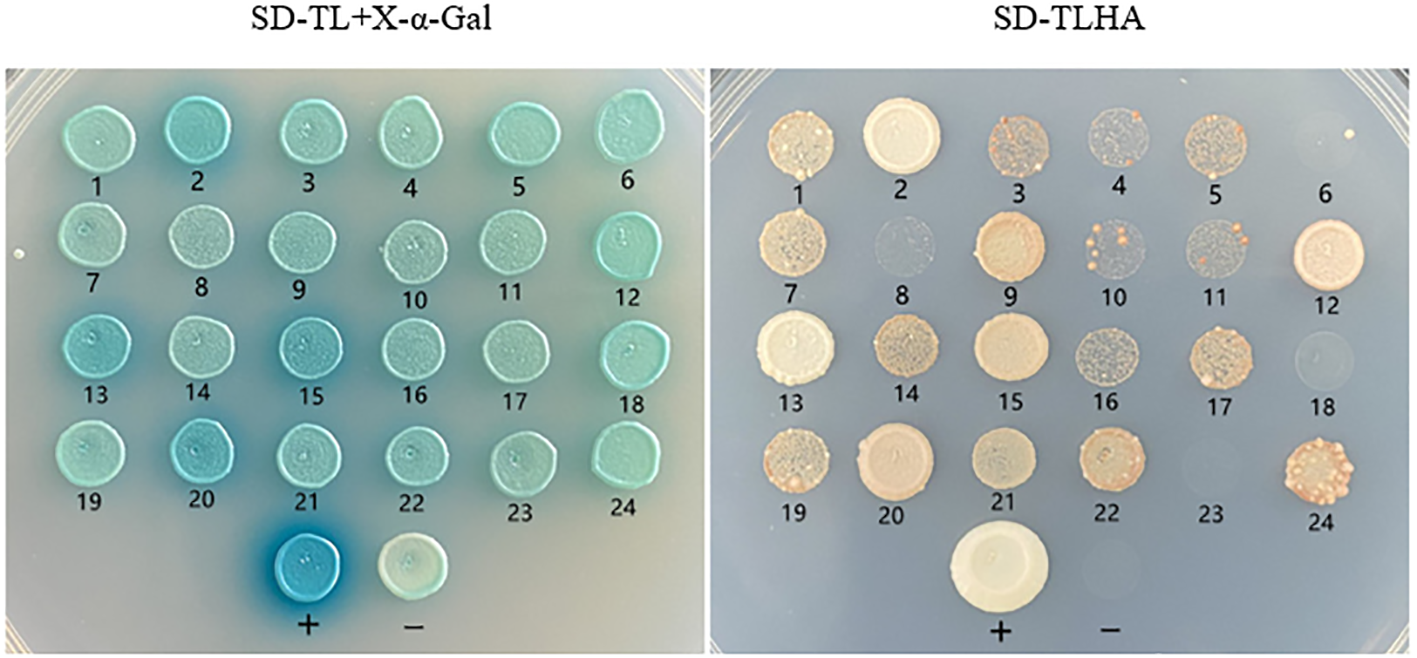
Figure 6

Abstract
Bangia fuscopurpurea is a widespread intertidal seaweed that is commercially cultured in China. This seaweed is frequently exposed to hyposalinity stress, but little is known about the adaptation mechanisms. Ascorbate−glutathione (AsA−GSH) cycle plays important roles in many organisms under a variety of abiotic stress, including hyposaline stress. In this study, we investigated the response of key metabolites and enzymes involved in the AsA−GSH cycle of B. fuscopurpurea under hyposalinity, with the addition of exogenous GSH and Lbuthionine-sulfoximine (BSO). The quantification of BfAPX gene expression was assessed across varied treatment regimens. And the putative interaction proteins of BfAPX were screened by yeast two hybrid system. It was found that under hyposalinity (15 and/or 0 psu), the content of reduced glutathione (GSH), total glutathione (GSH+ oxidized glutathione, GSSG) and cysteine, the ratio of GSH/GSSG and ascorbic acid (AsA)/ dehydroascorbic acid (DHA), and the activity of ascorbic acid peroxidase (APX) and monodehydroascorbate reductase (MDHAR) was significantly up-regulated. The hyposality-promoted GSH/GSSG was weakened while the glutathione reductase (GR) activity was promoted by adding exogenous GSH and BSO. The hyposality-promoted AsA/DHA ratio was strengthened by exogenous GSH but weakened by BSO. The dehydroascorbate reductase (DHAR) activity had no significant changes either with or without exogenous GSH under all salinities, while DHAR activity together with DHA content was enhanced by BSO. The expression of APX gene markedly increased under hyposalinity+BSO treatment. Putative interacting proteins of APX, including glutamate dehydrogenase 1a and fructose diphosphate aldolase, were identified through screening. The results indicated that the AsA−GSH cycle was involved in response of B. fuscopurpurea to hyposalinity by means of increasing GSH/GSSG ratio (through promoting GSH biosynthesis pathway and GSH regeneration from GSSG by GR catalyzation) and AsA/DHA ratio (promoting AsA regeneration through MDHAR). These findings would contribute to improve the aquaculture of this promising economic species and unveil how intertidal seaweeds address the global climate challenges.
1 Introduction
Bangia fuscopurpurea is widespread along marine shores from cold to subtropical zones (Wang et al., 2008). It prefers to inhabiting the upper intertidal zones, where it experiences wide fluctuations in external salinity, long periods of desiccation, as well as long exposure to high irradiance due to ebb and flow tide (Karsten, 1999). Salinity is one of the primary factors restricting the growth, development and biodiversity of organisms in intertidal zones and estuaries (Jahnke and White, 2003; Parida and Das, 2005). Coastal ecosystems worldwide are facing intense and diverse pressure caused by global climate change (Harley et al., 2006). Global warming will increase glacier melting and rainfall that leads to change in seawater salinity. Desalination causes abiotic stress to marine organisms (Poloczanska et al., 2013). In particular, intertidal seaweeds, which are alternately immersed in seawater and exposed to air due to periodic tide rhythm, are susceptible to severe hypersaline and hyposaline stress. B. fuscopurpurea is a promising commercial intertidal seaweed. It contains a large amount of proteins, free amino acids, polysaccharides, vitamins and minerals. Because of its high nutritional value and delicious flavor, B. fuscopurpurea has been one of the most popular marine vegetables and commercially cultured in South China since 1990s. Similar to laver, the intertidal mudflat culture mode is applied for this species, where it frequently suffers a large amount of rainfall and land runoff inflow (Wang et al., 2008). Therefore, it is of great significance to study the mechanism of B. fuscopurpurea in response to hyposaline stress.
B. fuscopurpurea has a strong tolerance to hyposalinity. A considerable early studies have found that this species can live in freshwater after step by step of transferring, and once supposed that B. fuscopurpurea may be the same species as the freshwater Bangia atropurpurea (Geesink, 1973; Reed, 1980). Our previous studies revealed that under hyposaline stress, the photosynthetic system of B. fuscopurpurea responded quickly, suggested that this alga has high photosynthetic capacity to survive during low tide, even during heavy rainfall (Wang et al., 2018; Wei et al., 2020). We further found that the “glutathione metabolism” pathway was one of the most significantly affected pathways, with some key functional genes up-regulated (Wang et al., 2019a), no burst of oxygen free radicals was detected, and the activity of various antioxidant enzymes including glutathione reductase (GR) was up-regulated in B. fuscopurpurea during hyposaline stress (Wang et al., 2019b). These findings suggest that glutathione (GSH) may be involved in B. fuscopurpurea resistance to hyposaline stress.
GSH is a key antioxidant associated with the regeneration of ascorbic acid (AsA) in the AsA−GSH cycle, which is an important pathway for clearance of reactive oxygen species (ROS) under kinds of stress (Devi et al., 2020). GSH, AsA, dehydroascorbic acid (DHAR), monodehydroascorbate reductase (MDHAR), ascorbate peroxidase (APX), and GR are the main components of the AsA−GSH system. APX consumes AsA to catalyze the reduction of H2O2 to H2O, thereby reducing or eliminating the toxicity of H2O2; then AsA is oxidized to monodehydroascorbic acid (MDHA); part of MDHA is reduced to AsA under the catalyzation of MDHAR, and the other part is oxidized to DHA. DHA reacts with GSH to return to AsA under the catalyzation of DHAR. The oxidized glutathione (GSSG) produced in this process is reduced to GSH under the catalysis of GR (Mittler, 2002). AsA−GSH cycle plays important roles in maintaining antioxidant capacity and signal transduction in plants. It has been reported that AsA−GSH mediated antioxidant metabolism functions in Neopyropia (Porphyra) yezoensis and Neoporphyra (Porphyra) haitanensis, two economic species in Bangiaceae, under abiotic stress (Yu et al., 2020).
To reveal the mechanism of B. fuscopurpurea adapting to hyposaline stress, the response of key metabolites and enzymes in the AsA−GSH cycle was studied under hyposalinity. It has been reported that adding exogenous GSH can effectively mitigate the damage caused by salt stress in higher plants (Hua et al., 2003). Thus, the response of AsA−GSH cycle in B. fuscopurpurea were further studied with the addition of exogenous GSH and L-buthionine-sulfoximine (BSO), the specific inhibitor of GSH biosynthesis. We hope this study would help to improve the aquaculture of this promising economic seaweed species and contribute to unveil how marine organisms address the global climate challenges.
2 Materials and methods
2.1 Sample collection
Thalli of B. fuscopurpurea were collected from Qingdao, Shandong (36.06°N, 120.20°E), China, in April 2021, and rinsed several times to remove epiphytic algae and sludge from the surface. The thalli were cultured in filtered sterilized natural seawater (salinity of ~30 psu, enriched with 2 mg/L NaNO3-N, 1 mg/L KH2PO4-P), in Qingdao, under 14°C, 40 μmol photons m−2 s−1, pH 8.0, 12 h:12 h L: D (Wang et al., 2018; Wei et al., 2020). After 3 days of adaptation, the following experiments were performed.
2.2 Salinity, GSH and BSO treatment
Healthy thalli were cultured in mediums of natural seawater diluted with 0% (v:v), 50%, and 100% sterilized freshwater, i.e., salinity of ~ 30 psu, 15 psu, 0 psu, respectively, at 14°C, 40 μmol photons m−2 s−1, pH 8.0, 12 h:12 h L: D. Three sets of treatments were performed for each salinity: control, adding 25 mg/L GSH, and adding 1 mg/L BSO. The abbreviation of the treatment was shown in Table 1. About 3 g of thalli were cultured in 3000 mL triangular glass bottle. Each culture was enriched with 2 mg/L NaNO3-N and 1 mg/L KH2PO4-P, continuously aerated, and renewed every three days. And three replicates were performed for each treatment. All cultures were performed in intelligent light incubators (Jiangnan instrument factory, Ningbo, China). Samples were collected after 1 d and 5 d of treatment, respectively, for the following measurements. About 0.1 g thalli (fresh weight) were used for each measurement. After weighing, fresh thalli were immediately frozen in liquid nitrogen.
Table 1
| Abbreviation | CC | CG | CB | LAC | LAG | LAB | LBC | LBG | LBB |
|---|---|---|---|---|---|---|---|---|---|
| Salinity(psu) | 30 ± 0.5 | 30 ± 0.5 | 30 ± 0.5 | 15 ± 0.5 | 15 ± 0.5 | 15 ± 0.5 | 0~0.5 | 0~0.5 | 0~0.5 |
| Temperature (°C) | 14 | 14 | 14 | 14 | 14 | 14 | 14 | 14 | 14 |
| pH | 8.0 | 8.0 | 8.0 | 8.0 | 8.0 | 8.0 | 8.0 | 8.0 | 8.0 |
| NO3-1-N (mg/L) | 2 | 2 | 2 | 2 | 2 | 2 | 2 | 2 | 2 |
| PO43–P (mg/L) | 1 | 1 | 1 | 1 | 1 | 1 | 1 | 1 | 1 |
| GSH (mg/L) | – | 25 | – | – | 25 | – | – | 25 | – |
| BSO (mg/L) | – | – | 1 | – | – | 1 | – | – | 1 |
The main components in and the abbreviation of each treatment.
2.3 Measurement of the metabolites and antioxidant enzymes in AsA−GSH cycle
The content of reduced glutathione (GSH) and oxidized glutathione (GSSG) was assayed according to (Ellman, 1959; Griffith, 1980) by using the assay kit GSH-1-W and GSSG-1-W (Suzhou Comin Biotechnology, Suzhou, China), respectively. Briefly, total GSH (T-GSH, GSH + GSSG) was determined at 412 nm, by using 100 μL extracted solution, 300 μL yeast-GR (5U), 300 μL 5,5,-dithio-bis-nitro-benzoic acid (3 mM) and 300 μL NADPH (0.5 mM). GSSG was determined by the same method in the presence of 2-vinylpyridine at 27°C for 1 h to derivatize GSH before adding GR. The GSH content was calculated from the difference between T-GSH and GSSG. A standard curve of GSH was used for quantification. The ascorbic acid (AsA) content was determined according to the fast blue salt B colorimetric method (Szpikowska-Sroka and Połedniok, 2011) by using the assay kit ASA-1-W (Suzhou Comin Biotechnology, Suzhou, China). Briefly, AsA reacts with solid blue salt B in acetic acid solution to produce a yellow oxalhydrazide-2-hydroxybutyrolactone derivative with a peak absorbance at 420 nm. The dehydroascorbic acid (DHA) content was determined according to Margolis et al. (1990) by using the assay kit DHA-1-W (Suzhou Comin Biotechnology, Suzhou, China). An extinction coefficient at 265 nm of 18 mM−1 cm−1 was used to determine DHA. The cysteine content was measured by the colorimetric method using reduced phosphotungstic acid to produce tungsten blue (Kassell and Brand, 1938) by using the assay kit CYS-1-W (Suzhou Comin Biotechnology, Suzhou, China).
The dehydroascorbate reductase (DHAR) and monodehydroascorbate reductase (MDHAR) activity was assayed according to Ma and Cheng (2003) by using the assay kit DHAR-1-W and MDHAR-1-W (Suzhou Comin Biotechnology, Suzhou, China), respectively. The activity of DHAR was expressed as nmol of AsA produced per second and that of MDHAR was expressed as nmol of NADH oxidized per second. The glutathione reductase (GR) activity was measured by using the assay kit A062-1-1 (Nanjing Jiancheng Co., Nanjing, China). One unit of GR activity was defined as the amount that reduced 1 nmol GSSG per second. The glutathione S-transferase (GST) activity was assayed according to Habig et al. (1974) by using the assay kit A004-1-1 (Nanjing Jiancheng Co., Nanjing, China). The activity of GST was determined by measuring the rate of glutathione-chemical compound conjugate formation. The glutathione peroxidase (GPX) activity was determined according to Paglia and Valentine (1967) by using the assay kit A005-1-1 (Nanjing Jiancheng Co., Nanjing, China). GPX can catalyze the reaction of H2O2 with GSH to produce H2O and GSSG. The activity of GPX was expressed by the speed of its enzymatic reaction, through measuring the consumption of GSH in this enzymatic reaction. The ascorbate peroxidase (APX) activity was measured by monitoring the decrease in absorbance at 290 nm according to Nakano and Asada (1981) by using the assay kit APX-1-W (Suzhou Comin Biotechnology, Suzhou, China). The activity of APX was calculated in terms of nmol of AsA oxidized per second. The γ-glutamylcysteine synthetase (γ-GCS) activity was determined according to Sekura and Meister (1977) by using the assay kit GCL-1-W (Suzhou Comin Biotechnology, Suzhou, China). The activity of the above enzymes was expressed as per mg protein. So the content of soluble proteins was determined for each sample at the same time, which was measured by the BCA method (Smith et al., 1985).
After the above measurement, it was found that the activity of APX was the most significantly up-regulated under hyposalinity. As an antioxidant enzyme that directly scavenges H2O2 in the AsA−GSH cycle, APX shows important physiological role in response to oxidative stress in many plants. Thus, the relative expression of the B. fuscopurpurea APX gene (BfAPX) under hyposaline stress and the interaction between B. fuscopurpurea APX (BfAPX) and the other proteins was further studied.
2.4 RNA isolation and qRT-PCR
The total RNA was extracted with UNlQ-10 Column Trizol Total RNA Isolation Kit (Sangon Biotech, Shanghai, China). Approximately 100 ng of total RNA was reverse transcribed, and the first strand of cDNA was obtained by reverse transcription by using GeneRuler DNA Ladder Mix and Maxima Reverse Transcriptase (Thermo Fisher Scientific, Massachusetts, USA) as the manufacturer’s instructions. qRT-PCR experiment was performed using 2X SG Fast qPCR Master Mix (High Rox) (Bio Basic Inc, Markham ON, Canada) in the QuantStudioTM 1 Plus System (Thermo Fisher Scientific, Massachusetts, USA). Each sample was performed in triplicate and the relative expression of the BfAPX gene was calculated based on the 2-ΔΔCT method by using the B. fuscopurpurea Actin gene as an internal reference (Livak and Schmittgen, 2001). The primers used were listed in Table 2.
Table 2
| Gene (Primer) names | Primer sequences(5’→3’) |
|---|---|
| RT-PCR | |
| BfAPX-F | GGCTTCAACGACGCAGAGA |
| BfAPX-R | CAGCAGGGCCTTGTCAGAC |
| Actin-F | CGCCGTCGTCGATGAAGATCA |
| Actin-R | GACCGGCTCACCCACATTTGTT |
| Protein interaction analysis | |
| BfAPX-F | AAGGCCATTACGGCCATGGTTTCCGAGCTGGAG |
| BfAPX-R | CCGGCCGAGGCGGCCTCACGACCACACCGCACCCAG |
Primer sequences for molecular experiments.
2.5 Protein interaction analysis
To obtain more relative genes that response to hyposalinity stress, a cDNA library was constructed. About 5 g fresh gametophyte thalli of B. fuscopurpurea were collected after 48 h treatment of 100% freshwater. Total RNA was extracted using TRIzol (Invitrogen, California, USA) and isolated using Oligotex mRNA Mini kit (Qiagen, Duesseldorf, Germany) according to the manufacturer’s instructions. About 4.5 μg of RNA was used for synthesizing the first- and the double-strand cDNA. The cDNA fragments were ligated into the pGADT7 cloning vector as prey proteins, and were co-transformed into yeast competent cell Y187. In addition to culturing on SD/-Leu plates to select the transformants, a series of dilution of the transformed mixture was spread on SD/-Leu media to calculate the transformation efficiency and independent colonies. The monoclone was selected on the plate and PCR amplified, and the size of the inserted fragments in the library was determined based on electrophoresis. After culturing at 30°C for 5 days, the positive transformants were collected to form an yeast two hybrid (Y2H) library. The complete sequence of the BfAPX was obtained and deposited in GenBank (OQ459344). Based on the BfAPX sequence, the primers with restriction enzyme sites were designed (Table 2). The BfAPX was constructed on the pGBKT7 vector and used to screen the library. Auto-activation and toxicity detection of the bait plasmid pGBKT7-BfAPX was made according to the instructions of Clontech. The AH109 yeast transformant containing the correct pGBKT7-K185 bait plasmid was used as the receptor strain to prepare the receptive state. The plasmid of Y2H-BfAPX-pGADT7 library was transferred into it and coated with SD-Trp-Leu-His+5 mM 3AT plate. Continue to culture for 7 days after the removal of photocopy, and select the positive clone single colony from the screen library plate. A total of 24 initial positive clones were selected and transferred to SD-TL deficient plate for further culture of 2~3 days. The plasmids pGADT7-LargeT and pGBKT7-p53 were co-transformed as the positive control, taking the pGADT7-LargeT and pGBKT7-LaminC as the negative control. The plates were subject to β-galactosidase activity assay using X-α-Gal staining. The yeast culture temperature was 30°C. The inserted fragments of the identified positive interactions were sequenced (Sangon Biotech, Shanghai, China).
2.6 Measurement of chlorophyll fluorescence
The maximum quantum yield of photosystem II (Fv/Fm) was measured. About 0.1 g thalli were used for each determination. Before each measurement, the sample was kept in the dark for 15~20 min (Demmig et al., 1987). The Fv/Fm was measured by using an IMAGING−PAM (WALZ, Germany). The dark-adapted thalli were subject to 0.15 μmol photons m−2 s−1 measuring light (650 nm red LED) to get the initial chlorophyll fluorescence Fo level and then subject to 0.8 s of 4000 μmol photons m−2 s−1 saturation pulse to get the maximum chlorophyll fluorescence Fm. The Fv/Fm was calculated as: (Fm–Fo)/Fm (Bhagooli et al., 2021).
2.7 Statistics analysis
Triplicate measurements were taken for each culture. The data were analyzed using GraphPad Prism 7 and Origin 2021. Statistical significance among samples was tested with one-way Anova at a significance level of p < 0.05 using Origin 2021. Pearson correlation analysis was made using Origin2021, and standard Pearson correlation coefficients (r) were determined for each index versus all other indexes.
3 Results
3.1 Hyposalinity induced changes of the metabolite content in the AsA−GSH cycle
Under hyposaline stress, the GSH content increased significantly compared with the control (CC) (1.4~1.8 times). After the addition of exogenous GSH and BSO, the GSH content decreased under hyposaline stress (15 and 0 psu) (LAG, LAB<LAC; LBB<LBC) while increased at 30 psu (CG, CB>CC) (Figure 1A). With the extension of treatment time (on the 5th day), the GSH content at 0 psu increased either with or without exogenous GSH while the GSH content decreased sharply with addition of BSO. The GSH content at 15 psu decreased significantly either with or without exogenous GSH on the 5th day (p< 0.05), and the GSH content in the other experimental groups were the same as that on the 1st day (Figure 1A). By contrast, the GSSG content in all groups treated with hyposalinity or exogenous GSH/BSO was lower than that in control (p< 0.05), and the lower the salinity, the more it deceased (Figure 1B). The change of the T-GSH content was consistent with the change of GSH, increasing at low salinities and decreasing when GSH or BSO was added at low salinities (Figure 1C). The ratios of GSH/GSSG increased 17.7~25.9 times over the control level under hyposality, but the increase was mitigated after adding exogenous GSH (LAG<LAC、LBG<LBC) (Figure 1D). The GSH, T-GSH content and GSH/GSSG ratio of B. fuscopurpurea was the highest after 5 days treatment of freshwater (~ 0 psu), increasing over the control level by 3.6, 2.6, and 26.2 times, respectively. The increasing was weakened by exogenous GSH and especially by BSO.
Figure 1

The (A) reduced glutathione (GSH), (B) oxidized glutathione (GSSG), (C) GSH+GSSG and (D) GSH/GSSG level in B fuscopurpurea under different culture conditions. Data was Mean ± SD (n = 3). Different letters indicated significant differences (p< 0.05). The red dotted line indicates the level in the CC (100% seawater) group.
There was slight decrease of the AsA content under hyposalinities on the 1st day and the AsA content at 15 psu increased to over the control level on the 5th day (Figure 2A). Significant decrease in DHA content together with significant increase ratio of AsA/DHA was identified under hyposalities especially on the 1st day (Figure 2). Under different salinities, significant decrease of AsA content, and increase of DHA content was observed with the addition of BSO (p< 0.05) (Figure 2C). Under 15 and 30 psu, addition of exogenous GSH increased the content of AsA (p< 0.05), decreased the content of DHA, and increased the ratio of AsA/DHA (p< 0.05), with the highest increase occurring under 15 psu on the 1st day and under 0 psu on the 5th day. Under 0 psu, the content of AsA decreased while the content of DHA increased on the 1st day after addition of exogenous GSH, while the AsA content increased, DHA content decreased and ratio of AsA/DHA increased significantly on the 5th day (Figure 2).
Figure 2

The (A) ascorbic acid (AsA), (B) dehydroascorbic acid (DHA) and (C) AsA/DHA level in B fuscopurpurea under different culture conditions. Data was Mean ± SD (n = 3). Different letters indicated significant differences (p< 0.05). The red dotted line indicates the level in the CC (100% seawater) group.
3.2 Hyposalinity induced changes of antioxidant enzyme activity in the AsA−GSH cycle
Under hyposalinity, the GST activity decreased, and no significant difference was identified between the groups with and without exogenous GSH/BSO under the same salinity (p > 0.05) (Figure 3A). GPX activity increased significantly under salinity of 0 psu on the 5th day, which was further promoted by exogenous GSH (p< 0.05) (Figure 3B). As the key enzyme reducing GSSG to GSH in AsA−GSH cycle, the GR activity decreased significantly under 15 psu on the 1st day and then increased to the control level on the 5th day (p < 0.05). Slight increase of the GR activity was observed on the 5th day under 0 psu (p > 0.05). Addition of exogenous GSH and BSO decreased the GR activity under 30 psu (1st day), while increased the GR activity under 0 psu (5th day and 1st day, respectively) (Figure 3C). APX is the key enzyme that plays an antioxidant role in AsA−GSH cycle by consuming AsA. On the 1st day, the APX activity was higher under either hyposalinity or exogenous GSH/BSO treatments compared to the control (CC) while the enhancement under hyposalinity was weakened by exogenous BSO (Figure 3D). MDHA, the oxidation product of AsA, is very unstable and can be reduced into AsA by MDHAR. Under 0 psu, the MDHAR activity increased significantly (p< 0.05), which decreased after adding exogenous GSH but was still higher than under the other salinites. Under 15 psu, the MDHAR activity increased significantly on the 5th day compared to 30 psu and they were largely promoted by adding BSO on the 1st day and slightly induced by exogenous GSH on the 5th day (Figure 3E). In addition, MDHA can be partially metabolized into DHA independent on enzymes, which can be further catalyzed into AsA through DHAR. There was no significant difference in the DHAR activity under varying salinities with or without exogenous GSH, while the DHAR activity increased significantly with addition of BSO under all salinities (p< 0.05), which was the most under 30 psu (Figure 3F).
Figure 3

The (A) glutathione S-transferase (GST), (B) glutathione peroxidase (GPX), (C) glutathione reductase (GR), (D) ascorbate peroxidase (APX), (E) monodehydroascorbate reductase (MDHAR), and (F) dehydroascorbate reductase (DHAR) activity in B fuscopurpurea under different culture conditions. Data was Mean ± SD (n = 3). Different letters indicated significant differences (p< 0.05). The red dotted line indicates the level in the CC (100% seawater) group.
3.3 Hyposalinity induced changes of γ-glutamylcysteine synthetase activity and cysteine content
Under hyposaline stress, the cysteine content increased significantly compared with the control (CC) (p< 0.05). The maximum increase of cysteine content was observed under 0 psu on the 5th day (p< 0.05) (Figure 4A). With addition of BSO, there was no obvious change in the cysteine content under 30 psu; the cysteine content increased under 15 psu on the 1st day; there was a drop of the cysteine content under 0 psu, which was still significantly higher than that under the other salinities. Compared to 30 psu, γ-GCS activity increased significantly on the 1st day under 0 psu (p< 0.05). After addition of BSO, the γ-GCS activity decreased significantly under all salinities (p< 0.05) (Figure 4B).
Figure 4

The (A) cysteine content and (B) γ-glutamylcysteine synthetase (γ-GCS) activity in B fuscopurpurea under different culture conditions. Data was Mean ± SD (n = 3). Different letters indicated significant differences (p< 0.05). The red dotted line indicates the level in the CC (100% seawater) group.
3.4 Expression pattern of the APX gene under hyposalinity
The expression of BfAPX gene was significantly upregulated at 0 psu on the 1st day, which was significantly enhanced by BSO (p< 0.05) (Figure 5). While on the 5th day, the expression of BfAPX gene decreased under either hyposalinity or with BSO treatment. With the addition of GSH, the expression of BfAPX gene was significantly higher at 30 psu and 15 psu than at 0 psu on the 1th day; the expression of BfAPX gene significantly decreased at 30 psu and 15 psu but increased at 0 psu on the 5th day (Figure 5).
Figure 5

The relative expression of BfAPX gene under hypohyaline stress with actin gene as reference. Different letters indicated significant differences (p< 0.05). The red dotted line indicates the level in the CC (100% seawater) group.
3.5 Screening of putative interaction proteins of APX
The size of cDNA library was 1.25×107 CFU, the average size of inserted fragments was larger than 1200 bp, and the positive rate of B. fuscopurpurea cDNA library was 100%. The result of bait plasmid insertion fragment sequencing showed that the cDNA of BfAPX gene was successfully cloned and constructed on the bait vector of yeast two-hybrid. The auto-activation assay result showed that the control strain grew normally on SD-TL plates, while only the positive control can grow on SD-TLHA+ X- α- Gal plates and appeared blue. The growth status of pGADT7+ pGBKT7-APX transformant on the SD-TLHA+ X- α- Gal plate was the same as that of the negative control, and the MEL1 test result was also the same as that of the negative control. These results indicated that the bait fusion protein was well expressed without self-activation. Using the bait Y2H-BfAPX-pGADT7 to screen the B. fuscopurpurea cDNA library obtained a transformation efficiency of 1.59×105/ug, indicating that the library can well cover the B. fuscopurpurea cDNA library. A total of 20 positive clones were obtained and confirmed through re-streaking on select plates (Figure 6). The sequence information of these positive clones was shown in Table 3.
Figure 6
Yeast two-hybrid assay of BfAPX proteins in B fuscopurpurea stress response. SD-TL, SD/-Leu/-Trp. SD-TLH, SD/-Leu/-Trp/-His. SD-TLHA, SD/-Leu/-Trp/-His/-Ade (+ X -α- gal).
Table 3
| Number of Clones | NCBI Accession | NCBI Description |
|---|---|---|
| 1、15 | KV919651.1 | Porphyra umbilicalis isolate 4086291 unplaced genomic scaffold scaffold_1676, whole genome shotgun sequence |
| 2 | JX293833.1 | Pyropia yezoensis light-harvesting protein mRNA, complete cds |
| 3、19 | XM_035605065.2 | PREDICTED: Scophthalmus maximus glutamate dehydrogenase 1a (glud1a), mRNA |
| 5、16、21 | AB127048.1 | Porphyra yezoensis mRNA for fructose-bisphosphate aldolase, complete cds |
| 12 | XM_047895493.1 | Psilocybe cubensis uncharacterized protein (JR316_0009809), partial mRNA |
| 13 | MG459162.1 | Triticum aestivum isolate Dctg4 alpha-gliadin (Gli-D2) gene, complete cds |
| 17 | XM_040391757.1 | PREDICTED: Aegilops tauschii subsp. strangulata alpha/beta-gliadin A-II-like (LOC109760460), mRNA |
| 20 | NM_120562.3 | Arabidopsis thaliana Ribosomal S17 family protein (AT5G04800), mRNA |
| 24 | KV918803.1 | Porphyra umbilicalis isolate 4086291 unplaced genomic scaffold scaffold_96, whole genome shotgun sequence |
Positive clones that encoding different proteins.
3.6 Fv/Fm change during salinity treatment
The Fv/Fm was a little higher at 15 psu than at 30 psu on the 1st day and there as no significant difference of Fv/Fm between 15 psu and 30 psu on the 5th day. After adding GSH or BSO, the Fv/Fm at 15 psu decreased to below the control level (p< 0.05) on the 1st day while increased almost equal to the control level on the 5th day. The Fv/Fm was significantly lower at 0 psu than the control during the experiment, which was increased by addition of BSO on the 1st day (Figure 7).
Figure 7

The maximum quantum yield of photosystem II (Fv/Fm) in B fuscopurpurea under different culture conditions. Data was Mean ± SD (n = 9). Different letters indicated significant differences (p< 0.05). The red dotted line indicates the level in the CC (100% seawater) group.
3.7 The correlation analysis between the components of AsA−GSH cycle under different treatments
Under hyposalinity, the GSH content was negatively correlated with the content of GSSG (r=-0.70) and DHA (r=-0.84), and the activity of GR (r=-0.5) and GST (r=-0.75). The DHA content was negatively correlated with the cysteine content (r=-0.75), and the activity of γ-GCS (r=-0.58), MDHAR (r=-0.65), DHAR (r=-0.24) and GPX (r=-0.66). In contrast, T-GSH content was positively correlated with the cysteine content (r=0.87), and the activity of GPX (r=0.64) and MDHAR (r=0.66). The AsA content was positively correlated with the activity of DHAR (r=0.61), MDHAR (r=0.66) and APX (r=0.61) (Figure 8A).
Figure 8

Correlation analysis between the components of AsA−GSH cycle under (A) varying salinities, (B) varying salinities with exogenous GSH, and (C) varying salinities treated with BSO.
Under varying salinities treated with exogenous GSH, the GSH content was negatively correlated with the content of GSSG (r=-0.56) and DHA (r=-0.82) and the GST activity (r=-0.71). In contrast, T-GSH content was positively correlated with the AsA content (r=0.72). The AsA content was positively correlated with the activity of DHAR (r=0.78) and APX (r=0.67) (Figure 8B).
Under varying salinities treated with BSO, the GSH content was negatively correlated with the content of GSSG (r=-0.87), γ-GCS (r=-0.78), and the activity of APX (r=-0.54) and GST (r=-0.73). The DHA content was negatively correlated with the cysteine content (r=-0.59), and the activity of γ-GCS (r=-0.62) and GR (r=-0.77). In contrast, T-GSH content was positively correlated with the content of AsA (r=0.82) and cysteine (r=0.53), and the activity of γ-GCS (r=0.72), GR (r=0.78), APX (r=0.60) and MDHAR (r=0.54). The AsA content was positively correlated with the activity of γ-GCS (r=0.80), APX (r=0.52) and GR (r=0.78) (Figure 8C).
3.8 Outlining the AsA−GSH cycle of B. fuscopurpurea in response to hyposalinity
Based on the above findings, the response of AsA−GSH cycle in B. fuscopurpurea to hyposalinity was outlined (Figure 9). As a whole, under hyposalinity, the content of GSH, AsA and cysteine, and the activity of GPX, APX, γ-GCS and MDHAR increased, while the content of GSSG and DHA and the activity of GR and GST decreased, leading to the increase ratios of GSH/GSSG and AsA/DHA.
Figure 9

Response of the B. fuscopurpurea AsA−GSH cycle under hyposaline stress.
The addition of exogenous GSH or BSO had similar effect on the GSH−GSSG cycle, i.e., the content of GSH increased while the GSSG content and GR activity decreased under 30 psu (100% seawater, control). On the contrary, under hyposality, the content of GSH decreased while the GSSG content and GR activity increased. There was no significant change in the GST activity after adding exogenous GSH or BSO. The GPX activity was enhanced by exogenous GSH under 30 and 0 psu and was inhibited by BSO under 0 psu. With regard to the AsA−DHA cycle, there was nearly contrast effect caused by exogenous GSH and BSO. The content of AsA and the activity of APX and MDHAR was generally enhanced, while the DHA content was reduced under varying salinities with the addition of GSH. BSO reduced the AsA content and promoted the DHA content under all salinities. The activity of APX increased under 30 psu and decreased under hyposalinity by adding BSO. Exogenous GSH had no obvious effect on the activity of DHAR, which was significantly promoted by BSO under all salinities. BSO inhibited γ-GCS activity under all salinities (Figure 9).
4 Discussion
Fv/Fm is empirically used as a timely probe to reflect the physiological injury degree of plants under stress (Schreiber and Armond, 1978). According to the previous study, the Fv/Fm of B. fuscopurpurea decreased under hyposalinity at first, recovered rapidly within 1 d and then kept at the control level even in 100% freshwater (Wang et al., 2018; Wang et al., 2019a). In this study, the Fv/Fm kept at the control level under moderate hyposaline stress (i.e., 15 psu) but decreased significantly in 100% freshwater. The difference may be due to the different source of samples. The samples used in the previous studies (Wang et al., 2018; Wang et al., 2019a) came from a cultured population in Fujian, while they were from a wild populaiton in Qingdao in this study. Nevertheless, the content of GSH, the ratio of GSH/GSSG and AsA/DHA, and the activity of several enzymes in AsA−GSH cycle of this wild B. fuscopurpurea were significantly up-regulated at 0 psu during 5 days of experiment, supporting a positive reaction towards the stress. Morphologically, the thalli still looked in good condition at 0 psu, however, some of the thalli were decayed with addition of BSO on the 5th day, further suggesting the role of GSH in resisting hyposaline stress.
4.1 Induction of glutathione biosynthesis in B. fuscopurpurea under hyposalinity
Glutathione is a crucial antioxidant associated with regenerating AsA in the AsA−GSH cycle. Plants generally up-regulate the production of non-enzymatic antioxidants such as GSH under stressful environments that helps to neutralize or scavenge ROS (Noctor et al., 2012). Intracellular GSH can be accumulated to several-folds over the basal levels in a variety of plants including the seaweed—laver under a variety of stress (Ruiz and Blumwald, 2002; Schützendübel et al., 2002; Fatma et al., 2014; Yu et al., 2020). Our previous study showed that the “glutathione metabolism” pathway and the activity of GR was induced under hyposaline stress (Wang et al., 2019a; Wang et al., 2019b). The results of this study showed that under different levels of hyposalinity, the GSH content and GSH/GSSG ratio of B. fuscopurpurea did increase significantly (Figure 1). The most widely used indicator of the redox state of the GSH pool is the ratio of GSH/GSSG, which reflects the change of GSH and GSSG, and provides a dynamic indicator of oxidative stress (Jones, 2002). The ratio of GSH/GSSG under hyposalinity increased significantly on the 5th day compared to the 1st day, indicating that GSH−GSSG cycle played important rolds in B. fuscopurpurea under hyposaline stress. The increase in GSH content can be achieved from GSSG through GR catalyzation or de novo biosynthesis through the γ-glutamyl cycle. Under hyposalinity, the increase of GSH content in B. fuscopurpurea was accompanied by the decrease of GSSG content, meanwhile, the content of T-GSH increased (Figure 1). Changes in the total glutathione pool size occur predominantly through oxidant−induced changes in the expression and post-translational activity of enzymes involved in both cysteine and glutathione synthesis (Noctor et al., 2012). Positive correlation between T-GSH content and cysteine content (r=0.87), and between T-GSH content and γ-GCS activity (r=0.44) were observed under hyposaline stress (Figure 8). A very important factor controlling the plant glutathione level is availability of cysteine (Noctor et al., 2002). The upregulation of cysteine and GSH synthesis under stress may be related to sulfur assimilation and metabolism, which is regulated in a demand−driven manner (Koprivova and Kopriva, 2014; Koprivova and Kopriva, 2022). The cysteine content of B. fuscopurpurea increased significantly under hyposaline stress especially under 0 psu (Figure 4A). Moreover, agents (e.g., pherone and H2O2) that stimulate oxidative stress have been shown to rapidly increase γ-glutamylcysteine synthetase (γ-GCS) activity independently (Ochi, 1995; Krejsa et al., 2010). The γ-GCS activity of B. fuscopurpurea was significantly elevated under 0 psu (Figure 4B). Thus, we deduced that the GSH biosynthesis pathway of B. fuscopurpurea was induced under hyposaline stress.
Under hyposalinity, the addition of exogenous GSH and BSO weakened the hyposalinity−induced increase of the endogenous GSH content and ratio of GSH/GSSG (Figure 1). The γ-GCS and glutathione synthetase (GSS) catalyze biosynthesis of GSH through γ-glutamyl cycle, with γ-GCS being the rate−limiting enzyme (Meister, 1981). GSH has a feedback inhibition effect on the γ-GCS activity (Richman and Meister, 1975). BSO has the chemical structure similar to that of sulfur−rich GSH and can bind to γ-GCS in the presence of ATP and Mg2+, leading to phosphorylation inactivation of γ-GCS and thereby inhibiting the synthesis of GSH (Drew and Miners, 1984). The γ-GCS activity of B. fuscopurpurea decreased significantly with the addition of BSO under all salinities (Figure 4B). It was noteworthy that the addition of exogenous GSH and BSO increased endogenous GSH content (1.3~2.7 times) and the ratio of GSH/GSSG (2.9~7.2 times) at 30 psu (unstressful condition) (Figure 1A). Exogenous GSH increasing the endogenous GSH content has been observed in many plants (Yao et al., 2021; Keya et al., 2022). This may be due to the ability of exogenous GSH as a source of sulfur to supplement GSH (Kumar et al., 2003). In addition to endogenous synthesis, glutathione can also be taken up into the cell through the action of specific glutathione transporters (Bourbouloux et al., 2000). Here, putatively, neither consumption nor biosynthesis of endogenous GSH was significantly induced under the unstressful condition (30 psu), thus, the endogenous GSH content would be enhanced due to the supplementary effect of exogenous GSH. It has been proven that BSO treatment can elevate GSS activity (Drążkiewicz et al., 2010). GSS rapidly catalyzes the ligation of γ-glutamylcysteine and glycine to generate glutathione (Winkler et al., 2011; Park et al., 2017). GSS activity appears to be primarily controlled both at transcriptional level and by substrate availability (Liu et al., 2014). Therefore, BSO may activate B. fuscopurpurea GSS to synthesize GSH under the unstressful condition (i.e., salinity of 30 psu) when the γ-glutamylcysteine has not been excessively consumed.
4.2 GSH was repleted from GSSG through GR catalyzation in B. fuscopurpurea under hyposalinity
The GSH content and redox state of GSH−GSSG pool serves as an important signal in plant cells and participates in regulation of many metabolic processes (Noctor et al., 2012). As mentioned above, the glutathione biosynthesis pathway of B. fuscopurpurea was induced under hyposalinity that led to increase of GSH and T-GSH content. Besides, the increase of GSH can come from GSSG through GR catalyzing. GR is a key enzyme in maintaining the GSH content and redox status of the glutathione pool in plants (Mittler, 2002; Gill et al., 2013). In this study, we found that GR activity decreased under 15 psu on the 1st day, and at the same time, the content of GSSG decreased and the content of GSH increased significantly, indicating that GR was rapidly consumed to reduce GSSG into GSH at the early stage of hyposaline stress. It also implied that B. fuscopurpurea triggered the de novo biosynthesis pathway of GSH instead of increasing the expression of GR to meet the high demand of GSH.
By day 5, the GR activity increased under hyposalinity especially under 0 psu compared to 30 psu, but was still below the initial level. Comparatively low GR activity allows appropriate changes in GSSG to mediate a signaling function (Foyer and Noctor, 2013). Elevating the GR level in transgenic tobacco cells significantly increased GSH level, however, there was little relationship between GR activity, cellular glutathione, and resistance to stress in different tobacco lines. In addition, manipulation of GR activity likely had negative impacts on the maintenance of other antioxidant defenses (Hancock, 2017). A set of antioxidant enzymes including GR of B. fuscopurpurea exhibited fluctuation in their activity during hyposalinity treatment, with the extent and time point of up-regulation increasing with the increasing of stress level (Wang et al., 2019b). The results suggested that the redox reaction of B. fuscopurpurea against hyposalinity was a dynamic process, with the functioning antioxidants/antioxidases differing during different periods or under different stress levels. At the early stage of hyposalinity stress, on one hand, GSSG was reduced by GR to rapidly increase the level of GSH; on the other hand, GSH was biosynthesized through γ-glutamyl cycle to strengthen the glutathione pool and maintain a high GSH/GSSG ratio. As the stress continued, the GR activity was promoted to regulate the redox state of GSH−GSSG pool. As can be seen in Figures 1, 3, 8, the overall change of GR activity was opposite to that of GSH while was up-regulated after the addition of GSH and BSO under hyposaline stress. It confirmed our inference: when the expression of GSH was inhibited, GSH would be supplemented through GSH−GSSG cycle by up-regulating GR.
4.3 GPX rather than GST was induced in B. fuscopurpurea under hyposaline stress
GPX and GST are antioxidant enzymes that both function by using GSH as a substrate. GPX can catalyze the reaction of GSH with lipid peroxides (ROOH) or H2O2 to reduce ROS, thereby blocking the burst of ROS and inhibiting the peroxidation progress of cells (Margis et al., 2008). It is the most efficient H2O2−removing system present in the cytosol of mammalian cells (Ursini and Maiorino, 2013). The expression and activity of GPX are enhanced when plants are subject to abiotic stresses such as high salinity (Avsian-Kretchmer et al., 1999) and drought (Ferreira Neto et al., 2013). The GPX activity in B. fuscopurpurea was significantly increased after 5 d of 0 psu stress, which was further increased by the addition of exogenous GSH while decreased by BSO (Figure 3). It has been observed that GPX recycling was dependent on GSH availability (Panday et al., 2020). A strong positive correlation between the GPX activity and the GSH content was identified under hyposalinity (Figure 8A). Considering the regulation modes of endogenous GSH by exogenous GSH/BSO (discussed above), the GPX activity of B. fuscopurpurea seemed to be affected by endogenous GSH signaling.
In contrast to GPX, the GST activity decreased under hyposaline stress, and no significant changes were observed with the addition of exogenous GSH or BSO. GST catalyzes the formation of glutathione S-conjugates between GSH and certain electrophilic substrates, leading to oxidization of GSH (Vaish et al., 2020). GSTs play important roles under a variety of stress conditions (Frova, 2003). They detoxify a variety of electrophilic compounds, including oxidized lipids, DNA, and catechol products generated by ROS. Metabolic compensation mechanisms exist between GPX and GST (Wyrwicka and Skłodowska, 2006). For example, when cucumbers were coped with acid rain stress, GST and GPX changed in reverse. In conclusion, B. fuscopurpurea seemed to mainly rely on the GPX to catalyze GSH−GSSG redox pathway under hyposaline stress, rather than the detoxification metabolic pathway through GST catalyzing conjugation of GSH with electrophilic compounds.
4.4 The ratio of AsA/DHA was enhanced in B. fuscopurpurea under hyposaline stress that was catalyzed by MDHAR rather than DHAR
DHAR is a key enzyme in the ASA−GSH cycle linking the GSH−GSSG pool to the AsA−DHA pool. GSH can be converted into GSSG through DHAR, at the same time DHA is reduced to AsA to regulate the cellular homeostasis of AsA−DHA (Deutsch, 2000). The AsA−GSH is an important pathway for scavenging ROS in plants. However, there was no significant change in the activity of DHAR in B. fuscopurpurea under hyposaline stress and after adding exogenous GSH. The reaction between GSH and DHA is also regulated by other enzymes like glutaredoxins (thioltransferases), protein disulfide isomerases, and a kunitz-type trypsin inhibitor (Trümper et al., 1994; Morell et al., 1997) except for DHAR. B. fuscopurpurea may not exert an antioxidant effect through DHAR−driving AsA−GSH cycle under hyposaline stress. This was further evidenced by the response after the addition of BSO: the DHAR activity was significantly up-regulated (5~12 times), accompanied by a significant decrease in AsA content and a significant increase in DHA content under all salinities. BSO inhibits γ-GCS activity and therefore causes cysteine, one of its substrates, to accumulate (RüEgsegger et al., 1990). Cysteine is essential for DHAR activity (Shimaoka et al., 2003). BSO−induced cysteine accumulation was merely observed in B. fuscopurpurea under 15 psu on the 1st day, otherwise, there was a slight decrease of the cysteine content under hyposalinity (Figure 4A). BSO might deplete cysteine in vivo even though the mechanism of BSO action (i.e., inhibition of γ-GCS) might lead one to predict that BSO would cause a transient accumulation of cysteine (Standeven and Wetterhahn, 1991). At present, researches regarding DHAR are mainly focused on its catalyzing DHA to AsA (Foyer and Mullineaux, 1998). The function of DHAR in B. fuscopurpurea is worth further study.
In addition to GSH, ASA is also the most abundant low molecular weight non-enzymatic antioxidant in plant cells. Environmental stresses can induce an increase of plant endogenous AsA (Shalata et al., 2001). The content of AsA in B. fuscopurpurea only increased significantly under 15 psu on the 5th day. The AsA/DHA ratio increased significantly (1.2~2 times) under hyposaline stress, mainly due to the decrease of DHA content. The AsA/DHA ratio could be further improved when exogenous GSH was added (Figure 2). In addition to DHAR, MDHAR is involved in AsA regeneration reaction. Under hyposalinity, although there was no significant change in B. fuscopurpurea DHAR activity, the MDHAR activity was significantly induced under 100% freshwater (Figure 3). It seemed that the regeneration of AsA was catalyzed by MDHAR rather than DHAR.
APX catalyzes the reduction of H2O2 to H2O by using AsA (Shigeoka et al., 2002). BSO enhances APX activity during the early development of Brassica napus embryoid, thus reducing its AsA content in vivo, making DHA the most predominant form of the entire ascorbate pool (Stasolla et al., 2008). A similar phenomenon was found in this study, in which APX activity increased significantly after adding BSO under 30 psu, accompanied by a significant decrease in AsA content and AsA/DHA ratio, and a significant increase in DHA content, with the changing being enlarged along with treatment period. The expression of BfAPX gene was significantly higher than the control at the same time. It has been mentioned above that under 30 psu, BSO promoted an increase in the endogenous GSH content, DHAR activity and DHA content, indicating the complementary role of GSH and AsA in B. fuscopurpurea. Exogenous GSH could upregulate APX and AsA in higher plants (Yao et al., 2021; Li et al., 2022). The addition of exogenous GSH increased the AsA/DHA ratio, APX activity and expression of BfAPX gene in B. fuscopurpurea under hyposalinty, when the accumulation of endogenous GSH was weakened and the GSH/GSSG was lowered.
APXs are members of the class I peroxidases, which contain an heme group found in higher plants, green algae, red algae and protists (Kuo et al., 2020). As an antioxidant enzyme that directly scavenges H2O2 in the AsA−GSH cycle, APX shows important physiological role in response to oxidative stress in plants. In this study, APX was the most significantly elevated antioxidant enzyme in the AsA−GSH cycle under hyposalinty. The relative expression of BfAPX was significantly upregulated under hyposaline stress with exogenous BSO and increased with the increase of hyposaline stress. A light-harvesting protein, the glutamate dehydrogenase 1a and fructose-bisphosphate aldolase were screened out to be the putative interaction proteins of BfAPX. These interaction proteins are all directly or indirectly related to the antioxidant response to stress (Jin et al., 2015; Chen et al., 2018; Patipong et al., 2019).
5 Conclusions
The results indicated that the AsA−GSH cycle was involved in response of B. fuscopurpurea to hyposalinity by means of increasing GSH/GSSG ratio (through promoting GSH biosynthesis pathway and GSH regeneration from GSSG by GR catalyzation) and AsA/DHA ratio (promoting AsA regeneration through MDHAR). Furthermore, several proteins that function in stress resistance were identified to putatively interact with B. fuscopurpurea APX, such as light-harvesting protein, the glutamate dehydrogenase 1a and fructose-bisphosphate aldolase. These findings contributed to unveil how intertidal seaweeds adapt to hyposaline stress, how marine organisms address the global climate challenge, and improve the aquaculture of this promising economic seaweed species. However, there is still lack of relevant researches related to this both economically and ecologically important seaweed species. The metabolic pathway and function mechanism of AsA−GSH cycle in B. fuscopurpurea requires further investigation based on the present findings, such as the response of DHAR, the empirical key enzyme connecting AsA−GSH cycle, and how the interaction proteins cooperate with BfAPX under stress.
Statements
Data availability statement
The datasets presented in this study can be found in online repositories. The names of the repository/repositories and accession number(s) can be found in the article/supplementary material.
Author contributions
Conceptualization: CN, WW. Investigation: CN, HY. Methodology: CN, ZL, HY. Formal analysis: CN, WW. Validation: CN, XL, WW. Data curation: CN, WW. Writing—original draft: CN. Writing—review and editing: WW, PZ. Supervision: WW. Funding acquisition: WW. All authors have read and agreed to the published version of the manuscript. All authors contributed to the article and approved the submitted version.
Funding
This work was supported by the National Key R&D Program of China ‘Scientific and Technological Innovation of Blue Granary’ (2018YFD0901504), the National Natural Science Foundation of China (31672630), the earmarked fund for CARS-50, Shandong Province Key Research and Development Program (2022LZGC004, 2021LZGC004), the Central Public-interest Scientific Institution Basal Research Fund (2020TD27).
Conflict of interest
The authors declare that the research was conducted in the absence of any commercial or financial relationships that could be construed as a potential conflict of interest.
Publisher’s note
All claims expressed in this article are solely those of the authors and do not necessarily represent those of their affiliated organizations, or those of the publisher, the editors and the reviewers. Any product that may be evaluated in this article, or claim that may be made by its manufacturer, is not guaranteed or endorsed by the publisher.
References
1
Avsian-Kretchmer O. Eshdat Y. Gueta-Dahan Y. Ben-Hayyim G. (1999). Regulation of stress-induced phospholipid hydroperoxide glutathione peroxidase expression in citrus. Planta.209, 469–477. doi: 10.1007/s004250050750
2
Bhagooli R. Mattan-Moorgawa S. Kaullysing D. Louis Y. D. Gopeechund A. Ramah S. et al . (2021). Chlorophyll fluorescence – a tool to assess photosynthetic performance and stress photophysiology in symbiotic marine invertebrates and seaplants. Mar. pollut. Bulletin.165, 112059. doi: 10.1016/j.marpolbul.2021.112059
3
Bourbouloux A. Shahi P. Chakladar A. Delrot S. Bachhawat A. K. (2000). Hgt1p, a high affinity glutathione transporter from the yeast Saccharomyces cerevisiae. J. Biol. Chem.275, 13259–13265. doi: 10.1074/jbc.275.18.13259
4
Chen Y.-E. Ma J. Wu N. Su Y.-Q. Zhang Z.-W. Yuan M. et al . (2018). The roles of Arabidopsis proteins of Lhcb4, Lhcb5 and Lhcb6 in oxidative stress under natural light conditions. Plant Physiol. Biochem.130, 267–276. doi: 10.1016/j.plaphy.2018.07.014
5
Demmig B. Winter K. KrüGer A. Czygan F.-C. (1987). Photoinhibition and zeaxanthin formation in intact leaves: a possible role of the xanthophyll cycle in the dissipation of excess light energy. Plant Physiol.84, 218–224. doi: 10.1104/pp.84.2.218
6
Deutsch J. C. (2000). Dehydroascorbic acid. J. Chromatogr A881, 299–307. doi: 10.1016/s0021-9673(00)00166-7
7
Devi Y. Dasgupta M. Mandal J. Sahoo M. (2020). Role of ascorbate–glutathione (AsA–GSH) pathways in phytophthora leaf blight disease resistance in taro (Colocasia esculenta l. schott). Int. Res. J. Pure Appl. Chem.21 (12), 66-75. doi: 10.9734/irjpac/2020/v21i1230240
8
Drążkiewicz M. Skórzyńska-Polit E. Krupa Z. (2010). Effect of BSO-supplemented heavy metals on antioxidant enzymes in Arabidopsis thaliana. Ecotoxicology Environ. Safety.73, 1362–1369. doi: 10.1016/j.ecoenv.2010.06.004
9
Drew R. Miners J. O. (1984). The effects of buthionine sulphoximine (BSO) on glutathione depletion and xenobiotic biotransformation. Biochem. Pharmacol.33, 2989–2994. doi: 10.1016/0006-2952(84)90598-7
10
Ellman G. L. (1959). Tissue sulfhydryl groups. Arch. Biochem. Biophysics.82, 70–77. doi: 10.1016/0003-9861(59)90090-6
11
Fatma M. Asgher M. Masood A. Khan N. A. (2014). Excess sulfur supplementation improves photosynthesis and growth in mustard under salt stress through increased production of glutathione. Environ. Exp. Botany.107, 55–63. doi: 10.1016/j.envexpbot.2014.05.008
12
Ferreira Neto J. R. Pandolfi V. Guimaraes F. C. Benko-Iseppon A. M. Romero C. Silva R. L. et al . (2013). Early transcriptional response of soybean contrasting accessions to root dehydration. PloS One8, e83466. doi: 10.1371/journal.pone.0083466
13
Foyer C. H. Mullineaux P. M. (1998). The presence of dehydroascorbate and dehydroascorbate reductase in plant tissues. FEBS Lett.425, 528–529. doi: 10.1016/s0014-5793(98)00281-6
14
Foyer C. H. Noctor G. (2013). Redox signaling in plants. Antioxid Redox Signal.18, 2087–2090. doi: 10.1089/ars.2013.5278
15
Frova C. (2003). The plant glutathione transferase gene family: genomic structure, functions, expression and evolution. Physiologia Plantarum.119, 469–479. doi: 10.1046/j.1399-3054.2003.00183.x
16
Geesink R. (1973). Experimental investigations on marine and freshwater Bangia (rhodophyta) from the Netherlands. J. Exp. Mar. Biol. Ecology.11, 239–247. doi: 10.1016/0022-0981(73)90024-5
17
Gill S. S. Anjum N. A. Hasanuzzaman M. Gill R. Trivedi D. K. Ahmad I. et al . (2013). Glutathione and glutathione reductase: a boon in disguise for plant abiotic stress defense operations. Plant Physiol. Biochem. PPB70, 204–212. doi: 10.1016/j.plaphy.2013.05.032
18
Griffith O. W. (1980). Determination of glutathione and glutathione disulfide using glutathione reductase and 2-vinylpyridine. Analytical Biochem.106, 207–212. doi: 10.1016/0003-2697(80)90139-6
19
Habig W. H. Pabst M. J. Jakoby W. B. (1974). Glutathione s-transferases. the first enzymatic step in mercapturic acid formation. J. Biol. Chem.249, 7130–7139. doi: 10.1016/s0021-9258(19)42083-8
20
Hancock R. D. (2017). “Oxidative stress,” in Encyclopedia of applied plant sciences, 2nd ed. Eds. ThomasB.MurrayB. G.MurphyD. J. (Oxford: Academic Press), 27–35.
21
Harley C. D. G. Randall Hughes A. Hultgren K. M. Miner B. G. Sorte C. J. B. Thornber C. S. et al . (2006). The impacts of climate change in coastal marine systems. Ecol. Letters.9, 228–241. doi: 10.1111/j.1461-0248.2005.00871.x
22
Hua C. Wang R. Liu Y. (2003). Effects of exogenous glutathione on active oxygen scavenging system in chloroplasts of rice under salt stress. J. Plant Physiol. Mol. Biol.29 (5), 415–420. doi: 10.3321/j.issn:1671-3877.2003.05.010
23
Jahnke L. S. White A. L. (2003). Long-term hyposaline and hypersaline stresses produce distinct antioxidant responses in the marine alga Dunaliella tertiolecta. J. Plant Physiol.160, 1193–1202. doi: 10.1078/0176-1617-01068
24
Jin L. Li D. Alesi G. Fan J. Kang H.-B. Zhou L. et al . (2015). Abstract 3046: Glutamate dehydrogenase 1 signals through antioxidant glutathione peroxidase 1 to regulate redox homeostasis and tumor growth. Cancer Res.75, 3046–3046. doi: 10.1158/1538-7445.AM2015-3046
25
Jones D. P. (2002). “Redox potential of GSH/GSSG couple: Assay and biological significance,” in Methods in enzymology. Eds. SiesH.PackerL. (Amsterdam, The Netherlands: Academic Press), 93–112.
26
Karsten U. (1999). Seasonal variation in heteroside concentrations of field-collected porphyra species (Rhodophyta) from different biogeographic regions. New Phytologist.143, 561–571. doi: 10.1046/j.1469-8137.1999.00477.x
27
Kassell B. Brand E. (1938). The photometric determination of cystine, cysteine, ascorbic acid, and related compounds with phosphotungstic acid. J. Biol. Chem.125, 115–129. doi: 10.1016/S0021-9258(18)73989-6
28
Keya S. S. Mostofa M. G. Mezanur Rahman M. Das A. K. Abiar Rahman M. Anik T. R. et al . (2022). Effects of glutathione on waterlogging-induced damage in sesame crop. Ind. Crops Products.185, 115092. doi: 10.1016/j.indcrop.2022.115092
29
Koprivova A. Kopriva S. (2014). Molecular mechanisms of regulation of sulfate assimilation: First steps on a long road. Front. Plant Science.5. doi: 10.3389/fpls.2014.00589
30
Koprivova A. Kopriva S. (2022). “Chapter 4 - role of plant sulfur metabolism in human nutrition and food security,” in Plant nutrition and food security in the era of climate change. Eds. KumarV.SrivastavaA. K.SuprasannaP. (Salt Lake City UT 84111 USA: Academic Press), 73–95.
31
Krejsa C. M. Franklin C. C. White C. C. Ledbetter J. A. Schieven G. L. Kavanagh T. J. (2010). Rapid activation of glutamate cysteine ligase following oxidative stress. J. Biol. Chem.285, 16116–16124. doi: 10.1074/jbc.M110.116210
32
Kumar C. Sharma R. Bachhawat A. K. (2003). Utilization of glutathione as an exogenous sulfur source is independent of γ-glutamyl transpeptidase in the yeast saccharomyces cerevisiae: evidence for an alternative gluathione degradation pathway. FEMS Microbiol. Letters.219, 187–194. doi: 10.1016/S0378-1097(03)00059-4
33
Kuo E. Y. Cai M.-S. Lee T.-M. (2020). Ascorbate peroxidase 4 plays a role in the tolerance of Chlamydomonas reinhardtii to photo-oxidative stress. Sci. Rep.10, 13287. doi: 10.1038/s41598-020-70247-z
34
Li X. Bao Z. Chen Y. Lan Q. Song C. Shi L. et al . (2022). Exogenous glutathione modulates redox homeostasis in okra (Abelmoschus esculentus) during storage. Postharvest Biol. Technology.195, 112145. doi: 10.1016/j.postharvbio.2022.112145
35
Liu H. He X. Ma Z. Xu W. Liu M. Liu H. (2014). Effects of exogenous GSH on the growth and AsA-GSH cycle in tamato seedlings under NaCl stress. J. Shihezi University(Natural Science).32, 265–271. doi: 10.13880/j.cnki.65-1174/n.2014.03.004
36
Livak K. J. Schmittgen T. D. (2001). Analysis of relative gene expression data using real-time quantitative PCR and the 2–ΔΔCT method. Methods.25, 402–408. doi: 10.1006/meth.2001.1262
37
Ma F. Cheng L. (2003). The sun-exposed peel of apple fruit has higher xanthophyll cycle-dependent thermal dissipation and antioxidants of the ascorbate–glutathione pathway than the shaded peel. Plant Science.165, 819–827. doi: 10.1016/S0168-9452(03)00277-2
38
Margis R. Dunand C. Teixeira F. K. Margis-Pinheiro M. (2008). Glutathione peroxidase family-an evolutionary overview. FEBS J.275, 3959–3970. doi: 10.1111/j.1742-4658.2008.06542.x
39
Margolis S. A. Paule R. C. Ziegler R. G. (1990). Ascorbic and dehydroascorbic acids measured in plasma preserved with dithiothreitol or metaphosphoric acid. Clin. Chem.36, 1750–1755. doi: 10.1093/clinchem/36.10.1750
40
Meister A. (1981). Metabolism and functions of glutathione. Trends Biochem. Sci.6, 231–234. doi: 10.1016/0968-0004(81)90084-0
41
Mittler R. (2002). Oxidative stress, antioxidants and stress tolerance. Trends Plant Science.7, 405–410. doi: 10.1016/s1360-1385(02)02312-9
42
Morell S. Follmann H. De Tullio M. Häberlein I. (1997). Dehydroascorbate and dehydroascorbate reductase are phantom indicators of oxidative stress in plants. FEBS Lett.414, 567–570. doi: 10.1016/s0014-5793(97)01074-0
43
Nakano Y. Asada K. (1981). Hydrogen peroxide is scavenged by ascorbate-specific peroxidase in spinach chloroplasts. Plant Cell Physiol.22, 867–880. doi: 10.1093/oxfordjournals.pcp.a076232
44
Noctor G. Gomez L. Vanacker H. Foyer C. H. (2002). Interactions between biosynthesis, compartmentation and transport in the control of glutathione homeostasis and signalling. J. Exp. Botany.53, 1283–1304. doi: 10.1093/jexbot/53.372.1283
45
Noctor G. Mhamdi A. Chaouch S. Han Y. Neukermans J. Marquez-Garcia B. et al . (2012). Glutathione in plants: an integrated overview. Plant Cell Environ.35, 454–484. doi: 10.1111/j.1365-3040.2011.02400.x
46
Ochi T. (1995). Hydrogen peroxide increases the activity of γ-glutamylcysteine synthetase in cultured Chinese hamster V79 cells. Arch. Toxicol.70, 96–103. doi: 10.1007/bf02733669
47
Paglia D. E. Valentine W. N. (1967). Studies on the quantitative and qualitative characterization of erythrocyte glutathione peroxidase. J. Lab. Clin. Med.70, 158–169. doi: 10.5555/URI:PII:0022214367900765
48
Panday S. Talreja R. Kavdia M. (2020). The role of glutathione and glutathione peroxidase in regulating cellular level of reactive oxygen and nitrogen species. Microvascular Res.131, 104010. doi: 10.1016/j.mvr.2020.104010
49
Parida A. K. Das A. B. (2005). Salt tolerance and salinity effects on plants: a review. Ecotoxicol Environ. Saf.60, 324–349. doi: 10.1016/j.ecoenv.2004.06.010
50
Park S.-I. Kim Y.-S. Kim J.-J. Mok J.-E. Kim Y.-H. Park H.-M. et al . (2017). Improved stress tolerance and productivity in transgenic rice plants constitutively expressing the Oryza sativa glutathione synthetase OsGS under paddy field conditions. J. Plant Physiol.215, 39–47. doi: 10.1016/j.jplph.2017.05.006
51
Patipong T. Ngoennet S. Honda M. Hibino T. Waditee-Sirisattha R. Kageyama H. (2019). A class I fructose-1,6-bisphosphate aldolase is associated with salt stress tolerance in a halotolerant cyanobacterium Halothece sp. PCC 7418. Arch. Biochem. Biophysics.672, 108059. doi: 10.1016/j.abb.2019.07.024
52
Poloczanska E. S. Brown C. J. Sydeman W. J. Kiessling W. Schoeman D. S. Moore P. J. et al . (2013). Global imprint of climate change on marine life. Nat. Climate Change.3, 919–925. doi: 10.1038/nclimate1958
53
RüEgsegger A. Schmutz D. Brunold C. (1990). Regulation of glutathione synthesis by cadmium in Pisum sativum l. Plant Physiol.93, 1579–1584. doi: 10.1104/pp.93.4.1579
54
Reed R. (1980). On the conspecificity of marine and freshwater Bangia in Britain. Br. Phycological J.15, 411–416. doi: 10.1080/00071618000650411
55
Richman P. G. Meister A. (1975). Regulation of γ-glutamyl-cysteine synthetase by nonallosteric feedback inhibition by glutathione. J. Biol. Chem.250, 1422–1426. doi: 10.1016/S0021-9258(19)41830-9
56
Ruiz J. M. Blumwald E. (2002). Salinity-induced glutathione synthesis in Brassica napus. Planta.214, 965–969. doi: 10.1007/s00425-002-0748-y
57
Schreiber U. Armond P. A. (1978). Heat-induced changes of chlorophyll fluorescence in isolated chloroplasts and related heat-damage at the pigment level. Biochim. Biophys. Acta (BBA) - Bioenergetics.502, 138–151. doi: 10.1016/0005-2728(78)90138-X
58
Schützendübel A. Nikolova P. Rudolf C. Polle A. (2002). Cadmium and H2O2-induced oxidative stress in Populus × canescens roots. Plant Physiol. Biochem.40, 577–584. doi: 10.1016/S0981-9428(02)01411-0
59
Sekura R. Meister A. (1977). γ-glutamylcysteine synthetase. further purification, "half of the sites" reactivity, subunits, and specificity. J. Biol. Chem.252, 2599–2605. doi: 10.1016/S0021-9258(17)40500-X
60
Shalata A. Mittova V. Volokita M. Guy M. Tal M. (2001). Response of the cultivated tomato and its wild salt-tolerant relative Lycopersicon pennellii to salt-dependent oxidative stress: The root antioxidative system. Physiologia Plantarum.112, 487–494. doi: 10.1034/j.1399-3054.2001.1120405.x
61
Shigeoka S. Ishikawa T. Tamoi M. Miyagawa Y. Takeda T. Yabuta Y. et al . (2002). Regulation and function of ascorbate peroxidase isoenzymes. J. Exp. Botany.53, 1305–1319. doi: 10.1093/jexbot/53.372.1305
62
Shimaoka T. Miyake C. Yokota A. (2003). Mechanism of the reaction catalyzed by dehydroascorbate reductase from spinach chloroplasts. Eur. J. Biochem.270, 921–928. doi: 10.1046/j.1432-1033.2003.03452.x
63
Smith P. K. Krohn R. I. Hermanson G. T. Mallia A. K. Gartner F. H. Provenzano M. D. et al . (1985). Measurement of protein using bicinchoninic acid. Analytical Biochem.150, 76–85. doi: 10.1016/0003-2697(85)90442-7
64
Standeven A. M. Wetterhahn K. E. (1991). Tissue-specific changes in glutathione and cysteine after buthionine sulfoximine treatment of rats and the potential for artifacts in thiol levels resulting from tissue preparation. Toxicol. Appl. Pharmacol.107, 269–284. doi: 10.1016/0041-008X(91)90208-V
65
Stasolla C. Belmonte M. F. Tahir M. Elhiti M. Khamiss K. Joosen R. et al . (2008). Buthionine sulfoximine (BSO)-mediated improvement in cultured embryo quality in vitro entails changes in ascorbate metabolism, meristem development and embryo maturation. Planta.228, 255–272. doi: 10.1007/s00425-008-0735-z
66
Szpikowska-Sroka B. Połedniok J. (2011). Spectrophotometric determination of l-ascorbic acid in pharmaceuticals. J. Analytical Chem.66, 941–945. doi: 10.1134/S1061934811100145
67
Trümper S. Follmann H. Häberlein I. (1994). A novel-dehydroascorbate reductase from spinach chloroplasts homologous to plant trypsin inhibitor. FEBS Lett.352, 159–162. doi: 10.1016/0014-5793(94)00947-3
68
Ursini F. Maiorino M. (2013). “Glutathione peroxidases,” in Encyclopedia of biological chemistry, 2nd ed. (Waltham: Academic Press), 399–404.
69
Vaish S. Gupta D. Mehrotra R. Mehrotra S. Basantani M. K. (2020). Glutathione s-transferase: a versatile protein family. 3 Biotech.10, 321. doi: 10.1007/s13205-020-02312-3
70
Wang W. Li X. Zhu J. Liang Z. Liu F. Sun X. et al . (2019b). Antioxidant response to salinity stress in freshwater and marine Bangia (Bangiales, rhodophyta). Aquat. Botany.154, 35–41. doi: 10.1016/j.aquabot.2018.12.008
71
Wang W. Shen Z. Sun X. Liu F. Liang Z. Wang F. et al . (2018). Photosynthetic response of Bangia fuscopurpurea (Bangiales, rhodophyta) towards dehydration and hyposalinity. Biologia.73, 333–337. doi: 10.2478/s11756-018-0040-7
72
Wang W. Shen Z. Sun X. Liu F. Liang Z. Wang F. et al . (2019a). De novo transcriptomics analysis revealed a global reprogramming towards dehydration and hyposalinity in Bangia fuscopurpurea gametophytes (Rhodophyta). J. Appl. Phycology.31, 637–651. doi: 10.1007/s10811-018-1501-7
73
Wang W. Zhu J. Xu P. Xu J. Lin X. Huang C. et al . (2008). Characterization of the life history of Bangia fuscopurpurea (Bangiaceae, rhodophyta) in connection with its cultivation in China. Aquaculture.278, 101–109. doi: 10.1016/j.aquaculture.2008.01.008
74
Wei J. Li X. Ma D. Wang W. Liang Z. Li G. et al . (2020). Effects of salinity and Na3VO4 stress on photosynthetic physiology of Bangia. Prog. Fishery Sci. 41 (5), 141–149. doi: 10.19663/j.issn2095-9869.20190628003
75
Winkler A. Njålsson R. Carlsson K. Elgadi A. Rozell B. Abraham L. et al . (2011). Glutathione is essential for early embryogenesis – analysis of a glutathione synthetase knockout mouse. Biochem. Biophys. Res. Commun.412, 121–126. doi: 10.1016/j.bbrc.2011.07.056
76
Wyrwicka A. Skłodowska M. (2006). Influence of repeated acid rain treatment on antioxidative enzyme activities and on lipid peroxidation in cucumber leaves. Environ. Exp. Botany.56, 198–204. doi: 10.1016/j.envexpbot.2005.02.003
77
Yao M. Ge W. Zhou Q. Zhou X. Luo M. Zhao Y. et al . (2021). Exogenous glutathione alleviates chilling injury in postharvest bell pepper by modulating the ascorbate-glutathione (AsA-GSH) cycle. Food Chem.352, 129458. doi: 10.1016/j.foodchem.2021.129458
78
Yu B. Yang J. Niu J. Wang G. (2020). Antioxidant responses to hyperosmolarity stress in the intertidal Pyropia yezoensis (Bangiales, rhodophyta). Algal Res.48, 101930. doi: 10.1016/j.algal.2020.101930
Summary
Keywords
antioxidant, AsA–GSH cycle, Bangia fuscopurpurea , chlorophyll fluorescence, hyposalinity stress, interaction protein
Citation
Niu C, Wang W, Yao H, Liang Z, Zhang P and Lu X (2023) Ascorbate−glutathione cycle involving in response of Bangia fuscopurpurea (Bangiales, Rhodophyta) to hyposalinity. Front. Mar. Sci. 10:1174472. doi: 10.3389/fmars.2023.1174472
Received
26 February 2023
Accepted
29 March 2023
Published
12 April 2023
Volume
10 - 2023
Edited by
Hongyu Ma, Shantou University, China
Reviewed by
Li Tangcheng, Shantou University, China; Yahe Li, Ningbo University, China
Updates
Copyright
© 2023 Niu, Wang, Yao, Liang, Zhang and Lu.
This is an open-access article distributed under the terms of the Creative Commons Attribution License (CC BY). The use, distribution or reproduction in other forums is permitted, provided the original author(s) and the copyright owner(s) are credited and that the original publication in this journal is cited, in accordance with accepted academic practice. No use, distribution or reproduction is permitted which does not comply with these terms.
*Correspondence: Wenjun Wang, wjwang@ysfri.ac.cn
This article was submitted to Aquatic Physiology, a section of the journal Frontiers in Marine Science
Disclaimer
All claims expressed in this article are solely those of the authors and do not necessarily represent those of their affiliated organizations, or those of the publisher, the editors and the reviewers. Any product that may be evaluated in this article or claim that may be made by its manufacturer is not guaranteed or endorsed by the publisher.